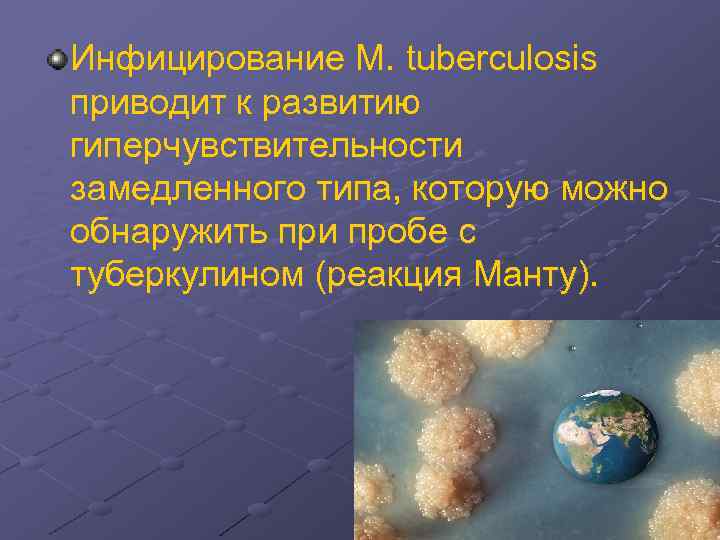
Инфицирование М. tuberculosis приводит к развитию гиперчувствительности замедленного типа, которую можно обнаружить при пробе

ТУБ.ppt
- Количество слайдов: 118

ГБОУ ВПО Чел. ГМА Минздравсоцразвития кафедра патологической анатомии ТУБЕРКУЛЁЗ доктор мед. наук, профессор Е. Л. Казачков, доктор мед. наук, профессор А. А. Казимирова Часть иллюстраций – из архивов профессоров Л. М. Гринберга, В. А. Цинзерлинга, Ю. Г. Пархоменко, атласов М. А. Пальцева с соавт, R. F. Cooke & B. Stewart и. , приложения к Robbins Pathology

ОСНОВНЫЕ ВОПРОСЫ Эпидемиологическая ситуация. Патоморфоз туберкулеза. Этиология. Вопросы патогенеза. Классификация. Классическая и современная патоморфология. Проблема генерализованного туберкулеза. Вопросы танатогенеза и формулировки диагноза. Особенности у детей Меры защиты медработников.

Туберкулёз (от лат. tuberculum — бугорок) — широко распространённое в мире инфекционное заболевание человека и животных с наклонностью к хроническому рецидивирующему течению , вызываемое различными видами микобактерий, как правило, Mycobacterium tuberculosis, зачастую социально-обусловленное, поражающее многие органы и ткани, но чаще – органы дыхания, сопровождающееся инвалидизацией и высокой смертностью больных

По данным ВОЗ ежегодно 8 -10 млн. новых случаев болезни. Инфицировано около 1/3 населения планеты. Бациллы Кальметта-Герена (БЦЖ) – вакцинный штамм возбудителя со сниженной вирулентностью – 50% эффекта (A. L. Ch. Calmette, C. Guerin (BCG). Фонд Б. Гейтса – 83 млн. $(2004) В России в 2005 г. – 119 тыс. заболевших, у 8, 5 тыс. это заболевание сопряжено с ВИЧ- инфекцией. Для сравнения: в США в 2002 г. было зарегистрировано 15075 случаев заболевания. Сегодня заболеваемость: в России – 83 на 100 тыс. населения; в Западной Европе – 7 -10 случаев на 100 тыс. населения; в США – около 4 на 100 тыс. населения. В России высока летальность от туберкулеза – 8 -12%. В 2004 г. в нашей стране умерло около 26 тыс. человек. А. П. Чехов и А. М. Горький на лечении в Ялте. 1901 г.

Ежегодно в мире регистрируется 9 млн. новых случаев заболеваний туберкулезом и 3 млн. случаев смерти от туберкулеза.

ПОСТАНОВЛЕНИЕ ПРАВИТЕЛЬСТВА РОССИЙСКОЙ ФЕДЕРАЦИИ ОТ 01. 12. 04 № 715 ОБ УТВЕРЖДЕНИИ ПЕРЕЧНЯ СОЦИАЛЬНО ЗНАЧИМЫХ ЗАБОЛЕВАНИЙ И ПЕРЕЧНЯ ЗАБОЛЕВАНИЙ, ПРЕДСТАВЛЯЮЩИХ ОПАСНОСТЬ ДЛЯ ОКРУЖАЮЩИХ Председатель Правительства Российской Федерации М. Фрадков

ПЕРЕЧЕНЬ СОЦИАЛЬНО ЗНАЧИМЫХ ЗАБОЛЕВАНИЙ Код заболеваний по МКБ-10 Наименование заболеваний 1. А 15 - А 19 Туберкулез 2. А 50 - А 64 Инфекции, передающиеся преимущественно половым путём 3. В 16; В 18. 0; В 18. 1 Гепатит В 4. В 17. 1; В 18. 2 Гепатит С 5. В 20 - В 24 Болезнь, вызванная вирусом иммунодефицита человека (ВИЧ) 6. С 00 - С 97 Злокачественные новообразования 7. Е 10 - Е 14 Сахарный диабет 8. F 00 - F 99 Психические расстройства и расстройства поведения 9. I 10 - I 13. 9 Болезни, характеризующиеся повышенным кровяным давлением

ТУБЕРКУЛЁЗ – БОЛЕЗНЬ НИЩЕТЫ

ТУБЕРКУЛЁЗ БОЛЕЗНЬ ЗАКЛЮЧЁННЫХ И БЕЖЕНЦЕВ

ОСНОВНЫЕ ПРИЧИНЫ РОСТА ЗАБОЛЕВАЕМОСТИ ТУБЕРКУЛЁЗОМ Социально-экономическая нестабильность в России, Усиление миграционных процессов из территорий стран СНГ, неблагополучных по туберкулезу и из зон национальных конфликтов. В этой связи во фтизиопедиатрии появилось новое приоритетное направление, ориентированное на изучение эпидемической опасности туберкулеза в социальнодезадаптированных группах населения, в учреждениях, где концентрируются эти дети (интернаты, приюты, приемникираспределители, поселения мигрантов, беженцев), Существует необходимость разработки новых организационно-методических подходов к проведению основных противотуберкулезных мероприятий среди указанных лиц.

ХАРАКТЕРИСТИКА СОВРЕМЕННОЙ ЭПИДЕМИОЛОГИЧЕСКОЙ СИТУАЦИИ ПРИ ТУБЕРКУЛЕЗЕ ОТЕЧЕСТВЕННЫМИ ПАТОЛОГАМИ И. П. Соловьева – эпидемия. В. В. Серов – реверсия туберкулеза. Л. М. Гринберг, Е. Л. Казачков – негативная фаза патоморфоза.

Роберт Кох (1843 – 1910) лауреат Нобелевской премии 1903 г. 1882 – выявлен возбудитель заболевания. Аэробные, неспорообразующие палочки. 1 -2 мкм. Восковая капсула. Кислотоустойчивые. Медленно растут в культуре – до 3 месяцев.

ВОЗБУДИТЕЛИ ТУБЕРКУЛЕЗА Облигатно патогенные для человека – M. tuberculosis и M. bovis. M. avium и M. intracellulare и другие потенциально патогенные микобактерии вызывают менее распространенные, чем туберкулез, болезни человека – микобактериозы. M. avium и M. intracellulare являются возбудителями туберкулеза у 10 -30% ВИЧинфицированных пациентов.

M. tuberculosis вызывает туберкулез у человека в 92 – 95% случаев. Резервуар возбудителя – люди, больные активным туберкулезом с поражением легких. Передача происходит при вдыхании возбудителя из воздуха в составе аэрозоля, образующегося при отхаркивании или чихании, или путем контакта с зараженными секретами больного. Возможен перкутанный (через кожу) путь заражения. Туберкулез не является высококонтагиозным заболеванием, но 25 – 50% лиц тесно и длительно контактирующих с бактериовыделителями инфицируются m. tuberculosis.

Врожденный туберкулез определяют как внутриутробное инфицирование при туберкулезном децидуите, плацентите или милиарном туберкулезе у матери с бактериемией; развитие первичного заболевания при аспирации инфицированных околоплодных вод или вследствие дыхания "рот в рот" лицом, осуществляющем родовспоможение.

МИКОБАКТЕРИЯ ТУБЕРКУЛЕЗА В ФАГОСОМЕ МАКРОФАГА (НЕЗАВЕРШЕННЫЙ ФАГОЦИТОЗ)

МИКОБАКТЕРИИ ТУБЕРКУЛЕЗА В ОКРАСКЕ ПО ЦИЛЮ-НИЛЬСЕНУ

СВЕЧЕНИЕ МИКОБАКТЕРИЙ В ЛЮМИНЕСЦЕНТНОМ СВЕТЕ

Особенности отличающие туберкулёз от других инфекций Первое – это убиквитарность (от лат. ubique — повсюду) туберкулеза в эпидемиологическом, клиническом и морфологическом отношении.

Особенности отличающие туберкулёз от других инфекций Второе — это двуликость туберкулеза — в зависимости от соотношения иммунитета и аллергии он может быть проявлением как инфицированности, так и болезни. Поэтому установить инкубационный период при туберкулезе невозможно.

Особенности отличающие туберкулёз от других инфекций Третье — выраженный полиморфизм клинико-морфологических проявлений туберкулеза и хроническое волнообразное его течение с чередованием вспышек и ремиссий.

Заразиться туберкулезом — не значит заболеть (заболевает только 3— 15 % инфицированных). Важно различать понятия «инфицирование» и «заболевание» .

Варианты течения 1) 2) 3) 4) Проникшую в легкое микобактерию поглощают макрофаги - начало инфицирования организма. После инфицирования возможно несколько исходов (вариантов течения): инфекция не развивается (кожная проба негативная); развитие инфекционного заболевания с быстрой прогрессией (первичный туберкулез); латентная туберкулезная инфекция, при которой иммунные механизмы препятствуют прогрессии заболевания; латентная туберкулезная инфекция с реактивацией и развитием активного туберкулеза через месяцы или годы.
Инфицирование М. tuberculosis приводит к развитию гиперчувствительности замедленного типа, которую можно обнаружить при пробе с туберкулином (реакция Манту).

Макрофаги (Ag) Патогенез CD 4+ТH 0 лимфоциты CD 4+ТН 1 лимфоциты Активация макрофагов (вновь прибывших) CD 4+ТН 1 лимфоциты клетки памяти Активация CD 8+ цитотоксических Т-клеток Реакция ГЗТ Туберкулезная гранулема

ПАТОГЕНЕЗ 1. 2. 3. В патогенезе туберкулеза играют роль три важнейших аспекта: Возбудитель способен персистировать в организме, сохранять вирулентность и устойчивость к завершенному фагоцитозу; Формирование противотуберкулезного иммунитета сопряжено с развитием гиперчувствительности замедленного типа; Гиперчувствительность сопровождается специфическим повреждением тканей и развитием творожистого (казеозного) некроза.

Патогенез туберкулеза у впервые контактирующего иммунокомпетентного человека основан на развитии клеточно -опосредованного иммунитета, который обеспечивает резистентность организма и приводит к развитию тканевой гиперчувствительности к антигенам возбудителя (клеточноопосредованной гиперчувствительности IV типа).

Патогенное действие M. tuberculosis связано, главным образом, со способностью избегать губительного влияния макрофагов и вызывать реакции гиперчувствительности замедленного типа. Корд-фактор клеточной стенки туберкулезной палочки поражает мембраны митохондрий макрофага, а сульфатиды ингибируют фагосомолизосомальное слияние, вследствие чего фагоцитарные реакции носят незавершенный характер. Образуется нарушенная и недостаточно эффективная фаголизосома, возбудитель получает возможность жить и неконтролируемо размножаться в цитоплазме макрофагов (эндоцитобиоз).

МИКРОСКОПИЧЕСКИЕ ПРИЗНАКИ ТУБЕРКУЛЕЗНОЙ ИНФЕКЦИИ 1. «Казеозный» некроз с эпителиоидноклеточным отграничением. 2. Эпителиоидноклеточные гранулемы с центральным некрозом. 3. Специфическая грануляционная ткань. 4. Кислотоустойчивые микобактерии внутри и вне клеток. 5. Эпителиоидноклеточные гранулемы без некроза. 6. Эпителиоидноклеточные гранулемы с центральным абсцессом. 7. Гигантские многоядерные клетки Лангханса и клетки инородных тел.

МИКРОСКОПИЧЕСКИЕ ПРИЗНАКИ – «КАЗЕОЗНЫЙ» НЕКРОЗ С ОТГРАНИЧЕНИЕМ

Langhans Theodor (1839 -1915)

ЭПИТЕЛИОИДНО-ГИГАНТОКЛЕТОЧНОЕ ОТГРАНИЧЕНИЕ НЕКРОЗА

ЭПИТЕЛИОИДНОКЛЕТОЧНЫЕ ГРАНУЛЕМЫ С ЦЕНТРАЛЬНЫМ НЕКРОЗОМ

КЛАССИФИКАЦИИ ТУБЕРКУЛЕЗА Патологоанатомическая – А. И. Абрикосов, А. И. Струков. Клиническая – XI Съезд фтизиатров, приказ № 109. ВОЗ МКБ-10.

КЛАССИФИКАЦИЯ ТУБЕРКУЛЕЗА Туберкулезная интоксикация у детей и подростков: вираж туберкулиновых проб+признаки интоксикации+первичный комплекс не определяется. Первичный туберкулез. Гематогенно-диссеминированный туберкулез, включая внелегочный туберкулез. Вторичный туберкулез. Туберкулез в сочетании с пневмокониозами.

ПЕРВИЧНЫЙ ТУБЕРКУЛЕЗНЫЙ КОМПЛЕКС

Для первичного туберкулеза характерна высокая чувствительность тканей к микобактериям и их токсинам, которая обусловливает возможность развития токсико-аллергических тромбоваскулитов и склонность к распространению процесса.

При аэрогенном заражении в легких первичный аффект возникает субплеврально в наиболее хорошо аэрируемых сегментах чаще правого легкого — III, VIII, IX, X (особенно часто в III сегменте).

ПЕРВИЧНЫЙ ТУБЕРКУЛЕЗНЫЙ КОМПЛЕКС Первичный аффект – субплевральный фокус туберкулезной пневмонии с отграничением. Лимфангит – распространение инфекции по лимфатическим сосудам – дорожка к корню. Туберкулезный лимфаденит внутригрудных лимфоузлов – тотальный казеозный некроз. Кишечный туберкулезный комплекс (алиментарный путь заражения) – чрезвычайная редкость – коровье молоко – слепая кишка.

ПЕРВИЧНЫЙ ТУБЕРКУЛЕЗНЫЙ КОМПЛЕКС

ПЕРВИЧНЫЙ ТУБЕРКУЛЕЗНЫЙ КОМПЛЕКС Первичный аффект (1) Лимфангит (2) Лимфаденит (3)

ПЕРВИЧНЫЙ ЛЕГОЧНЫЙ АФФЕКТ

ТУБЕРКУЛЕЗ ЛИМФАТИЧЕСКОГО УЗЛА


ПЕРВИЧНЫЙ ТУБЕРКУЛЕЗНЫЙ КОМПЛЕКС В ФАЗЕ ЗАЖИВЛЕНИЯ – ОЧАГ ГОНА

ОЧАГ ГОНА В ЛЕГКОМ

ЗАЖИВШИЙ ЛЕГОЧНЫЙ АФФЕКТ (ГИАЛИНОЗ, ПЕТРИФИКАЦИЯ)

ЭРА ПЕРВИЧНОГО ТУБЕРКУЛЕЗА

К ПЕРВИЧНОМУ ТУБЕРКУЛЕЗУ ПРИНЯТО ОТНОСИТЬ ВСЕ СЛУЧАИ ПРОГРЕССИРОВАНИЯ ПЕРВИЧНОГО ТУБЕРКУЛЕЗНОГО КОМПЛЕКСА И ЕГО ХРОНИЧЕСКОЕ ТЕЧЕНИЕ

КЛИНИКО-МОРФОЛОГИЧЕСКИЙ ФОРМЫ ПЕРВИЧНОГО ТУБЕРКУЛЕЗА ХРОНИЧЕСКОЕ ТЕЧЕНИЕ ПЕРВИЧНОГО ТУБЕРКУЛЕЗНОГО КОМПЛЕКСА: - туберкулезный лимфаденит; - первичная туберкулезная каверна ПРОГРЕССИРОВАНИЕ ПЕРВИЧНОГО ТУБЕРКУЛЕЗНОГО КОМПЛЕКСА: - рост первичного аффекта – казеозная пневмония; - лимфожелезистый вариант – лимфонодулярная каверна с аденогенными осложнениями (лимфонодулобронхиальные и пищеводные свищи, сосудистые фистулы, кровотечения, аспирационные пневмонии); - генерализация процесса – милиарная, крупно-очаговая диссеминация, реже – туберкулезный сепсис (тифобациллез Ландузи); - смешанное.

ПЕРВИЧНЫЙ ТУБЕРКУЛЕЗ (лимфо-железистый вариант прогрессирования)

Туберкулез внутригрудных лимфатических узлов, осложненный милиарным туберкулезом легких

ПЕРВИЧНЫЙ ТУБЕРКУЛЕЗ ЛЕПТОМЕНИНГИТ

ХРОНИЧЕСКОЕ ТЕЧЕНИЕ ПЕРВИЧНОГО ТУБЕРКУЛЕЗА (лимфаденит)

ЭРА ГЕМАТОГЕННОГО ТУБЕРКУЛЕЗА

ГЕМАТОГЕННО-ДИССЕМИНИРОВАННЫЙ ТУБЕРКУЛЕЗ (МИЛИАРНЫЙ, ПОСЛЕПЕРВИЧНЫЙ) 1) генерализованный 2) с преимущественным поражением легких (острый – милиарный, подострый и хронический) 3) с преимущественно внелегочными поражениями

МИЛИАРНЫЙ ТУБЕРКУЛЕЗ ЛЕГКИХ

МИЛИАРНЫЙ ТУБЕРКУЛЁЗ ЛЁГКИХ

ГЕМАТОГЕННО-ДИССЕМИНИРОВАННЫЙ ТУБЕРКУЛЕЗ

ТУБЕРКУЛЕЗНЫЕ БУГОРКИ В ЛЕГКИХ ПРИ МИЛИАРНОМ ТУБЕРКУЛЕЗЕ

ШТАМПОВАННЫЕ КАВЕРНЫ ПРИ ГЕМАТОГЕННОМ ТУБЕРКУЛЁЗЕ

ТУБЕРКУЛЕЗ ЯИЧКА И ЕГО ПРИДАТКА

ТУБЕРКУЛЕЗНЫЙ ЭПИДИДИМИТ

ТУБЕРКУЛЕЗ ТАЗОБЕДРЕННОГО И КОЛЕННОГО СУСТАВОВ

ДЕСТРУКТИВНЫЙ ТУБЕРКУЛЕЗ ПОЗВОНКОВ. КЛИНОВИДНЫЙ ПЕРЕЛОМ ТЕЛА ПОЗВОНКА

ТУБЕРКУЛЕЗНЫЙ СПОНДИЛИТ

ТУБЕРКУЛЕЗНЫЙ СПОНДИЛИТ. ГОРБ

ТУБЕРКУЛЕЗ ПОЧЕК С ФОРМИРОВАНИЕМ КАВЕРН

ТУБЕРКУЛЕЗ ПОЧЕК Поражение клубочка почки (окраска по Циль-Нильсену) Поражение клубочка почки

КАВЕРНОЗНЫЙ ТУБЕРКУЛЕЗ ПОЧКИ

ТУБЕРКУЛЕЗ ПЕЧЕНИ. ТУБЕРКУЛЕЗНЫЙ АСЦИТ

ПРОЯВЛЕНИЯ МИЛИАРНОГО ТУБЕРКУЛЕЗА Милиарные бугорки в печени

ПРОЯВЛЕНИЯ МИЛИАРНОГО ТУБЕРКУЛЕЗА Милиарные бугорки в селезенке

ТУБЕРКУЛЕЗНЫЙ ЛЕПТОМЕНИНГИТ

ТУБЕРКУЛЁЗНЫЙ ЛЕПТОМЕНИНГИТ

ПОРАЖЕНИЕ ВЕЩЕСТВА ГОЛОВНОГО МОЗГА И МЯГКОЙ МОЗГОВОЙ ОБОЛОЧКИ ПРИ ТУБЕРКУЛЕЗЕ

ТУБЕРКУЛЁЗ КОЖИ

ЭРА ВТОРИЧНОГО ТУБЕРКУЛЕЗА


ВТОРИЧНЫЙ ТУБЕРКУЛЕЗ Эндогенная экзацербация – L-формы микобактерии туберкулеза. (exacerbatio; лат. exacerbo раздражать, отягощать, обострение) Экзогенная суперинфекция. Преимущественное поражение легких.

ФОРМЫ ВТОРИЧНОГО ТУБЕРКУЛЕЗА 1 - Очаговый (острый и фиброзноочаговый). 2 - Инфильтративный. 3 - Туберкулома. 4 - Туберкулезная (казеозная) пневмония. 5 - Кавернозный туберкулез. 6 - Фиброзно-кавернозный туберкулез. 7 - Цирротический туберкулез.

ФОРМЫ ВТОРИЧНОГО ТУБЕРКУЛЕЗА

ИНКАПСУЛИРОВАННЫЙ ФОКУС КАЗЕОЗНОГО НЕКРОЗА ДО 1 СМ В ДИАМЕТРЕ (фиброзно-очаговый туберкулез легких)

ФИБРОЗНО-ОЧАГОВЫЙ ТУБЕРКУЛЕЗ ЛЕГКИХ (очаги Симона)

ФИБРОЗНО-ОЧАГОВЫЙ ТУБЕРКУЛЕЗ ЛЕГКИХ

ИНФИЛЬТРАТИВНЫЙ ТУБЕРКУЛЕЗ – ОГРАНИЧЕННЫЙ ФОКУС ТУБЕРКУЛЕЗНОЙ ПНЕВМОНИИ (1 -2 СЕГМЕНТА)

ТУБЕРКУЛОМА С РАСПАДОМ Инкапсулированный фокус казеозного некроза > 1 см в диаметре. Три типа: 1) гомогенная казеома; 2)слоистая туберкулома; 3)конгломеративная туберкулома.

ТРИ ТИПА ТУБЕРКУЛОМЫ

ИНФИЛЬТРАТИВНЫЙ ТУБЕРКУЛЕЗ ВЕРХНЕЙ ДОЛИ ЛЕГКОГО С РАСПАДОМ И ФОРМИРОВАНИЕМ ОСТРОЙ КАВЕРНЫ – ОСТРЫЙ КАВЕРНОЗНЫЙ ТУБЕРКУЛЕЗ

КАЗЕОЗНАЯ ПНЕВМОНИЯ

КАЗЕОЗНАЯ ПНЕВМОНИЯ

КАЗЕОЗНАЯ ПНЕВМОНИЯ (гранулематозная реакция)

ОСТРЫЙ КАВЕРНОЗНЫЙ ТУБЕРКУЛЁЗ Стенка острой каверны

ФИБРОЗНО-КАВЕРНОЗНЫЙ ТУБЕРКУЛЕЗ – ЛЕГОЧНАЯ ЧАХОТКА

ФИБРОЗНАЯ КАВЕРНА В ВЕРХНЕЙ ДОЛЕ ЛЕГКОГО С ДРЕНИРУЮЩИМ БРОНХОМ

ФИБРОЗНО-КАВЕРНОЗНЫЙ ТУБЕРКУЛЁЗ

ФИБРОЗНО-КАВЕРНОЗНЫЙ ТУБЕРКУЛЕЗ ТРЕХСЛОЙНАЯ ФИБРОЗНАЯ КАВЕРНА

ОТДАЛЕННЫЕ ПОСЛЕДСТВИЯ ТУБЕРКУЛЕЗА ЛЕГКИХ

ОСЛОЖНЕНИЯ ТУБЕРКУЛЕЗА Кахексия – прогрессирование. Кровотечение. Спонтанный пневмоторакс. Вторичный амилоидоз. Легочное сердце. ИСХОДЫ Выздоровление – относительное. Остаточные изменения (посттуберкулезные) – горб и пр. Инвалидизация – потеря органа и пр. Смерть от осложнений.

1921 г. – год рождения противотуберкулёзной вакцины bacillus Calmette. Guerin (BCG). Ветеринар ЖАН-МАРИ КАМИЛЬ ГЕРЕН (1872 -1961) Бактериолог ЛЕОН ШАРЛЬ АЛЬБЕРТ КАЛЬМЕТТ (1863 -1933)

В 1919 г. французские ученые Альберт Кальметт и Камиль Герен впервые получили вакцину против туберкулеза, использовав для этого микобактерии (возбудители туберкулеза) бычьего типа. Методом повторных пересевов был выведен ослабленный (аттенуированный) вид возбудителя, названный по имени авторов bacillus Calmette-Guerin (BCG). В русской транскрипции - БЦЖ.


Неблагоприятные последствия прививки БЦЖ принято называть БЦЖ-инфекцией или БЦЖит (BCG disease, BCGitis)

Осложнения, возникающие при вакцинации БЦЖ (по классификации, предложенной Международным союзом по борьбе с туберкулёзом ВОЗ в 1984 г. ): Категория 1: локальные поражения (подкожные инфильтраты, холодные абсцессы, язвы) и регионарные лимфадениты. Категория 2: персистирующая и диссеминированная БЦЖ-инфекция без летального исхода (волчанка, оститы). Категория 3: диссеминированная БЦЖ-инфекция, генерализованное поражение с летальным исходом, отмечаемое при врождённом иммунодефиците. Категория 4: пост-БЦЖ-синдром (узловатая эритема, кольцевидная гранулёма, высыпания).

ОСЛОЖНЕНИЯ ВАКЦИНАЦИИ БЦЖ

ОСЛОЖНЕНИЯ ВАКЦИНАЦИИ БЦЖ

ОСЛОЖНЕНИЯ ВАКЦИНАЦИИ БЦЖ

Роберт КОХ получил и предложил для определения степени сенсибилизации организма к антигенам туберкулезной палочки ТУБЕРКУЛИН (лимфа Коха). Барон Клеменс фон ПИРКЕ (18741929) – австрийский педиатр и патолог, стал применять туберкулин, скарифицируя кожу предплечья – накожная проба Пирке (1907). Шарль МАНТУ (1877 -1947) – французский бактериолог, модифицирован пробу Пирке, усовершенствуя метод введения туберкулина – внутрикожно (1908).

РЕАКЦИЯ МАНТУ

ПРОБЛЕМА СПИДА В РОССИИ – ЭТО ПРЕЖДЕ ВСЕГО ПРОБЛЕМА МИКОБАКТЕРИАЛЬНЫХ ИНФЕКЦИЙ

ГРУППЫ РИСКА Асоциальные лица (алкоголики, наркоманы, заключенные). Малообеспеченные слои населения. ВИЧ-инфицированные. Иммуносупрессивные пациенты. Рабочие пылевых профессий. Медицинские работники (патологоанатомические отделения, судебно-медицинские бюро и пр. )

ОСОБЕННОСТИ ТУБЕРКУЛЁЗА У ДЕТЕЙ В возрасте до двух лет часто отмечается возникновение туберкулезного сепсиса, милиарного туберкулеза, туберкулезного менингита У детей старшего возраста иммунная защита дает возможность остановить инфекционный процесс в области легких, поэтому чаще всего возникает туберкулез легких, внутригрудных лимфатических узлов

К группам социального риска заболевания туберкулезом относятся: Дети и подростки из социальнодезадаптированных семей, оставшиеся без попечения родителей (лица БОМЖ, воспитанники интернатных учреждений, приютов, приемников-распределителей для несовершеннолетних), из семей беженцев, вынужденных переселенцев и мигрантов, из многодетных, неполных и малообеспеченных семей. Эти группы детско-подросткового населения постоянно увеличиваются.

ВИЧ-СПИД ТУБЕРКУЛЕЗ НАРКОМАНИЯ АЛКОГОЛИЗМ УГРОЗА НАЦИОНАЛЬНОЙ БЕЗОПАСНОСТИ СТРАНЫ !

МЕРЫ ЗАЩИТЫ МЕДПЕРСОНАЛА Самая высокая профессиональная заболеваемость туберкулезом - ПАО, СМ Бюро. Каждая аутопсия – источник возможного заражения HIV + MDR TB. Органы дыхания. Кожа, слизистые оболочки. Разовая одежда. Маска, очки, перчатки. Минимальное использование воды. Ограничение вскрытий черепной коробки и спинного мозга. Проблема санитаров.



ТУБ.ppt